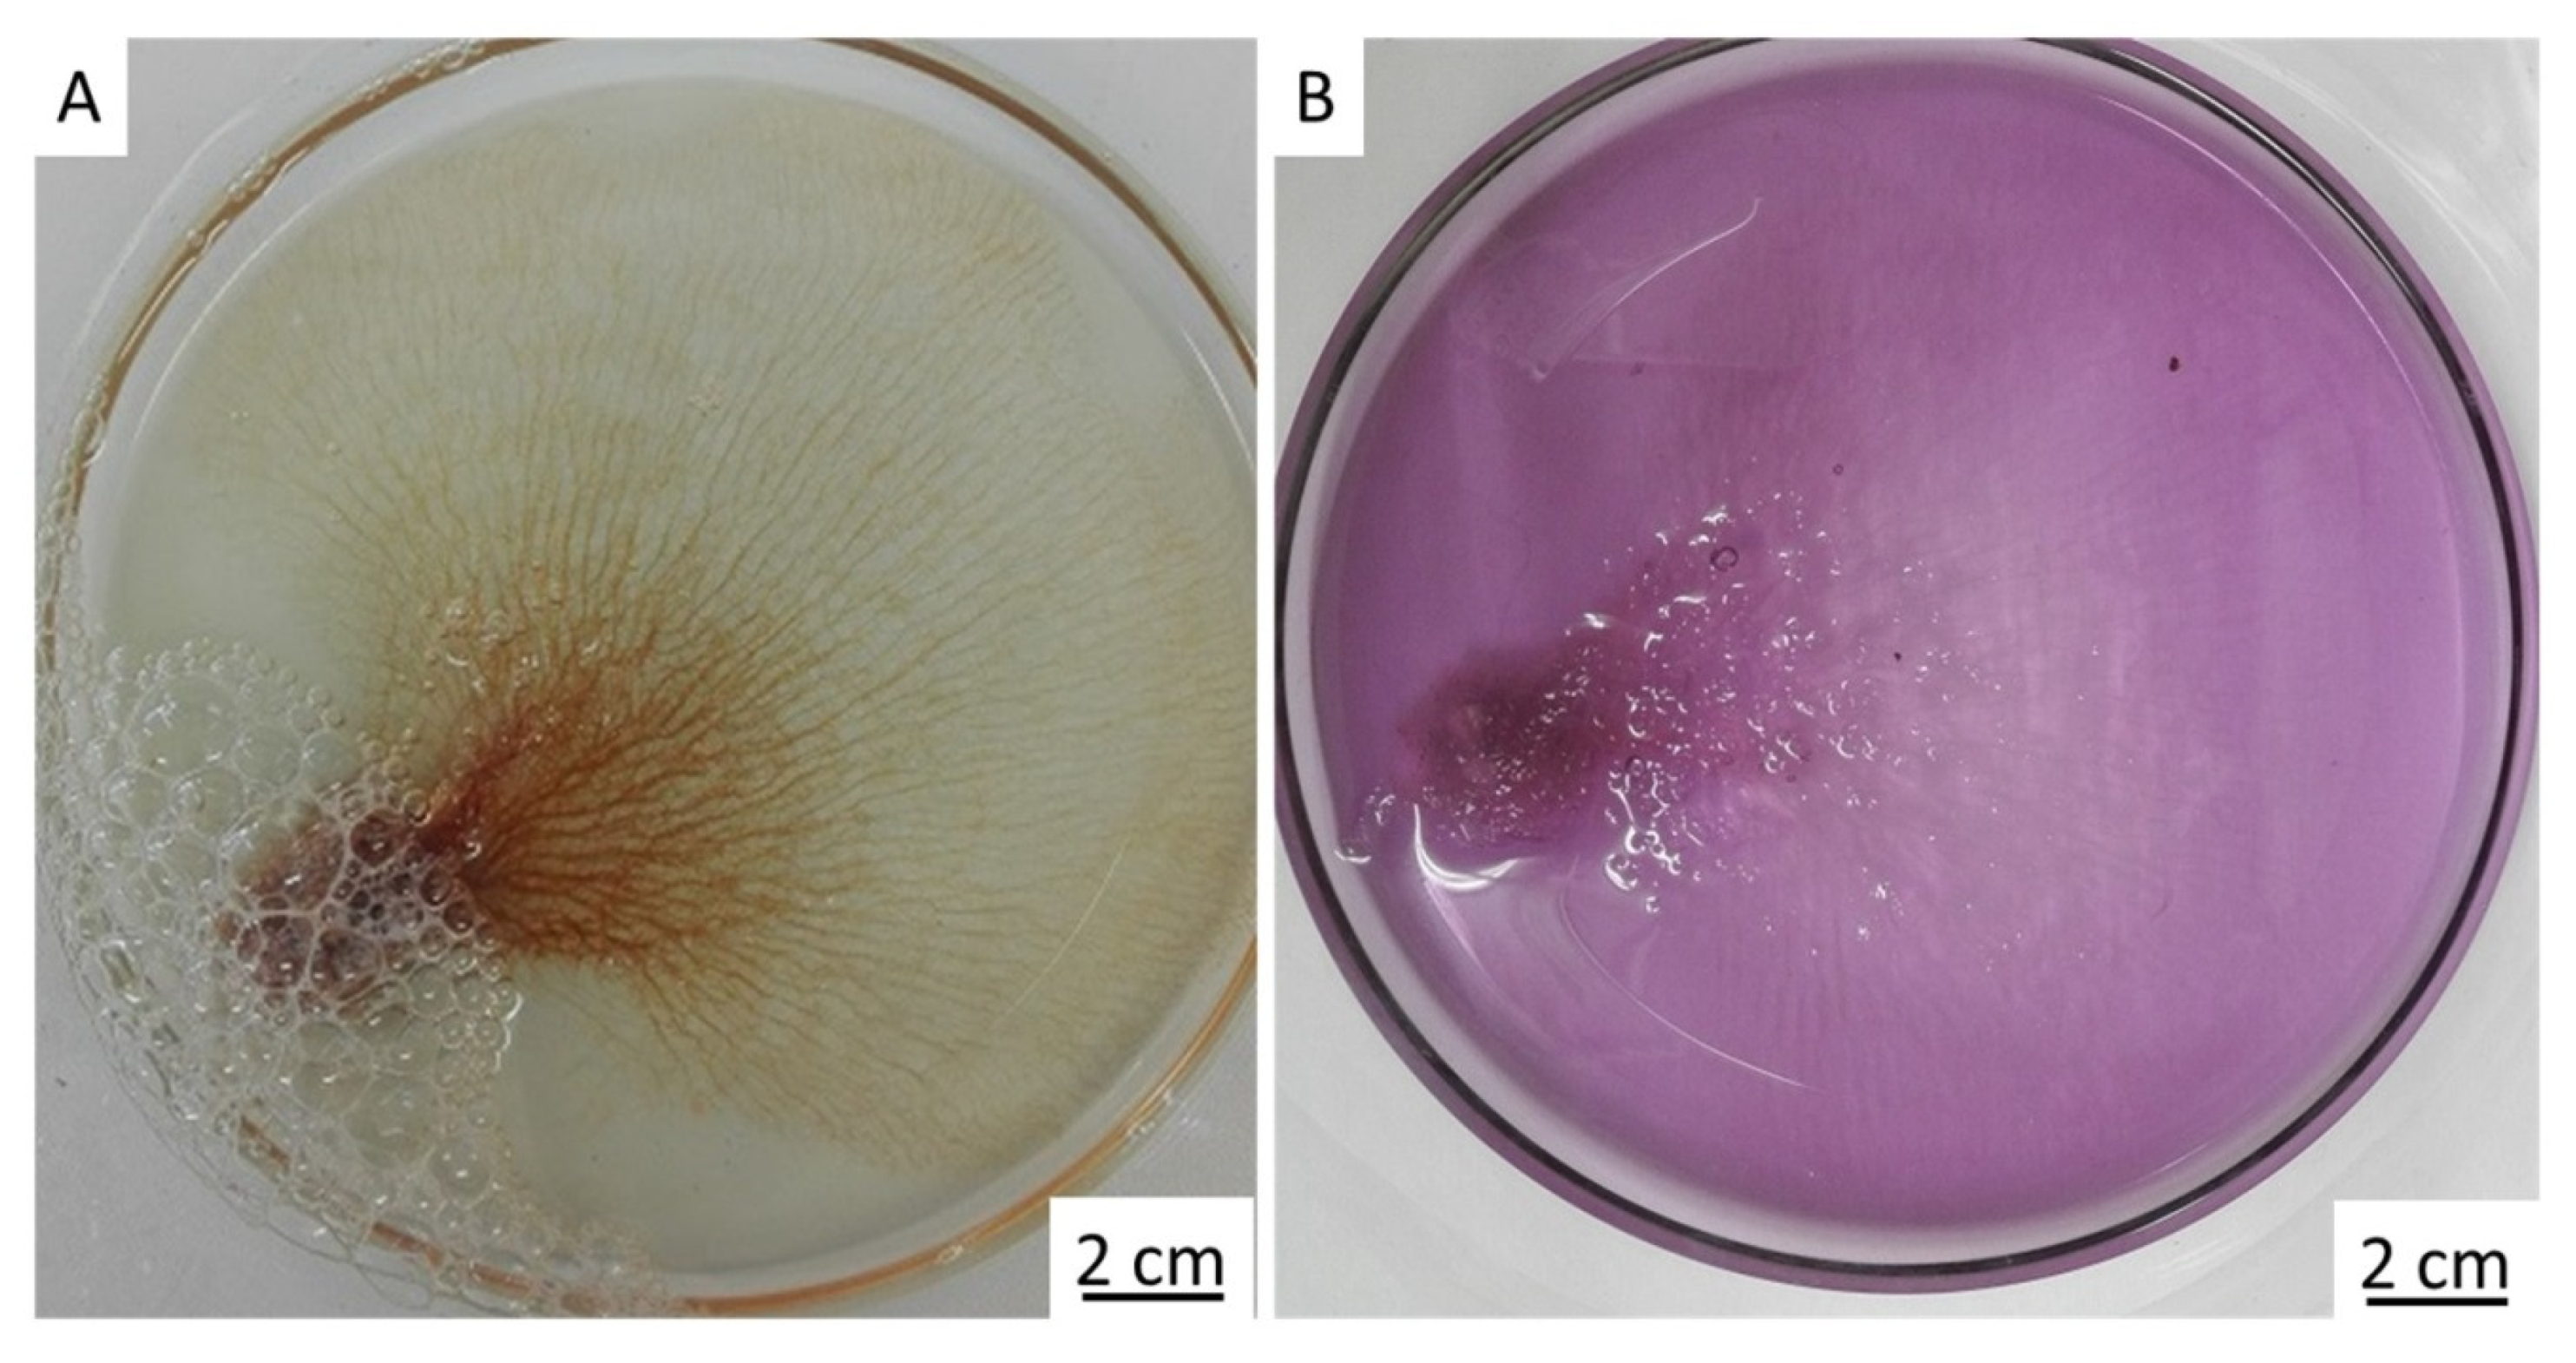
Marinedrugs 17 00574 g006 Marinedrugs 17 00574 g006

Naturally Drug-Loaded Chitin: Isolation and Applications
Abstract
1. Introduction
2. Results
3. Discussion
4. Materials and Methods
4.1. Location and Collection
4.2. Isolation of Chitinous Skeleton from the Sponge and Identification of Selected Bromotyrosines
4.3. Antimicrobial Activity of Chitin Matrix
4.4. Stereomicroscopy and Light Microscopy Imaging
4.5. Transmission Electron Microscopy (TEM), Scanning Electron Microscopy (SEM), and EDX
5. Conclusions
Supplementary Materials
Author Contributions
Funding
Acknowledgments
Conflicts of Interest
References
- Ehrlich, H.; Rigby, J.K.; Botting, J.P.; Tsurkan, M.V.; Werner, C.; Schwille, P.; Petrášek, Z.; Pisera, A.; Simon, P.; Sivkov, V.N.; et al. Discovery of 505-million-year old chitin in the basal demosponge Vauxia gracilenta. Sci. Rep. 2013, 3, 3497. [Google Scholar] [CrossRef] [PubMed]
- Mioso, R.; Marante, F.J.T.; Bezerra, R.D.S.; Borges, F.V.P.; Santos, B.V.D.O.; De Laguna, I.H.B. Cytotoxic compounds derived from marine sponges: A review (2010–2012). Molecules 2017, 22, 208. [Google Scholar] [CrossRef] [PubMed]
- Helber, S.B.; Hoeijmakers, D.J.J.; Muhando, C.A.; Rohde, S.; Schupp, P.J. Sponge chemical defenses are a possible mechanism for increasing sponge abundance on reefs in Zanzibar. PLoS ONE 2018, 13, e0197617. [Google Scholar] [CrossRef] [PubMed]
- Ebel, R.; Brenzinger, M.; Kunze, A.; Gross, H.J.; Proksch, P. Wound activation of protoxins in marine sponge Aplysina aerophoba. J. Chem. Ecol. 1997, 23, 1451–1462. [Google Scholar] [CrossRef]
- Green, D.W.; Howard, D.; Yang, X.; Kelly, M.; Oreffo, R.O.C. Natural marine sponge fiber skeleton: A biomimetic scaffold for human osteoprogenitor cell attachment, growth, and differentiation. Tissue Eng. 2003, 9, 1159–1166. [Google Scholar] [CrossRef] [PubMed]
- Jesionowski, T.; Norman, M.; Żółtowska-Aksamitowska, S.; Petrenko, I.; Joseph, Y.; Ehrlich, H. Marine spongin: Naturally prefabricated 3D scaffold-based biomaterial. Mar. Drugs 2018, 16, 88. [Google Scholar] [CrossRef] [PubMed]
- Ehrlich, H.; Wysokowski, M.; Zółtowska-Aksamitowska, S.; Petrenko, I.; Jesionowski, T. Collagens of poriferan origin. Mar. Drugs 2018, 16, 79. [Google Scholar] [CrossRef] [PubMed]
- Ehrlich, H.; Maldonado, M.; Spindler, K.-D.; Eckert, S.; Hanke, T.; Born, R.; Goebel, C.; Simon, P.; Heinemann, S.; Worch, H. First evidence of chitin as a component of the skeletal fibres of marine sponges. Part I. Verongidae (Demospongia: Porifera). J. Exp. Zool. B Mol. Dev. Evol. 2007, 308, 347–356. [Google Scholar] [CrossRef]
- Ehrlich, H.; Ilan, M.; Maldonado, M.; Muricy, G.; Bavestrello, G.; Kljajic, Z.; Carballo, J.L.; Schiaparelli, S.; Ereskovsky, A.; Schupp, P.; et al. Three-dimensional chitin-based scaffolds from Verongida sponges (Demospongiae: Porifera). Part I. Isolation and identification of chitin. Int. J. Biol. Macromol. 2010, 47, 132–140. [Google Scholar] [CrossRef]
- Ehrlich, H.; Shaala, L.A.; Youssef, D.T.A.; Zoltowska-Aksamitowska, S.; Tsurkan, M.; Galli, R.; Meissner, H.; Wysokowski, M.; Petrenko, I.; Tabachnick, K.R.; et al. Discovery of chitin in skeletons of non-verongiid Red Sea demosponges. PLoS ONE 2018, 13, 1–18. [Google Scholar] [CrossRef]
- Brunner, E.; Ehrlich, H.; Schupp, P.; Hedrich, R.; Hunoldt, S.; Kammer, M.; Machill, S.; Paasch, S.; Bazhenov, V.V.; Kurek, D.V.; et al. Chitin-based scaffolds are an integral part of the skeleton of the marine demosponge Ianthella basta. J. Struct. Biol. 2009, 168, 539–547. [Google Scholar] [CrossRef] [PubMed]
- Rohde, S.; Schupp, P.J. Growth and regeneration of the elephant ear sponge Ianthella basta (Porifera). Hydrobiologia 2012, 687, 219–226. [Google Scholar] [CrossRef]
- Mutsenko, V.V.; Gryshkov, O.; Lauterboeck, L.; Rogulska, O.; Tarusin, D.N.; Bazhenov, V.V.; Schütz, K.; Brüggemeier, S.; Gossla, E.; Akkineni, A.R.; et al. Novel chitin scaffolds derived from marine sponge Ianthella basta for tissue engineering approaches based on human mesenchymal stromal cells: Biocompatibility and cryopreservation. Int. J. Biol. Macromol. 2017, 104, 1955–1965. [Google Scholar] [CrossRef] [PubMed]
- Stepniak, I.; Galinski, M.; Nowacki, K.; Wysokowski, M.; Jakubowska, P.; Bazhenov, V.V.; Leisegang, T.; Ehrlich, H.; Jesionowski, T. A novel chitosan/sponge chitin origin material as a membrane for supercapacitors-preparation and characterization. RSC Adv. 2016, 6, 4007–4013. [Google Scholar] [CrossRef]
- Wysokowski, M.; Petrenko, I.; Stelling, A.L.; Stawski, D.; Jesionowski, T.; Ehrlich, H. Poriferan chitin as a versatile template for extreme biomimetics. Polymers (Basel) 2015, 7, 235–265. [Google Scholar] [CrossRef]
- Ehrlich, H. Chitin of poriferan origin as a unique biological material. In Blue Biotechnology: Production and Use of Marine Molecules; Bates, S.S., La Barre, S., Eds.; Wiley-VCH: Weinheim, Germany, 2019; pp. 821–854. [Google Scholar]
- Fromont, J.; Wahab, M.A.A.; Gomez, O.; Ekins, M.; Grol, M.; Hooper, J.N.A. Patterns of sponge biodiversity in the Pilbara, Northwestern Australia. Diversity 2016, 8, 21. [Google Scholar] [CrossRef]
- Bechmann, N.; Ehrlich, H.; Eisenhofer, G.; Ehrlich, A.; Meschke, S.; Ziegler, C.G.; Bornstein, S.R. Anti-tumorigenic and anti-metastatic activity of the sponge-derived marine drugs aeroplysinin-1 and isofistularin-3 against pheochromocytoma in vitro. Mar. Drugs 2018, 16, 172. [Google Scholar] [CrossRef]
- Kumar, M.S.; Adki, K.M. Marine natural products for multi-targeted cancer treatment: A future insight. Biomed. Pharmacother. 2018, 105, 233–245. [Google Scholar] [CrossRef]
- Niemann, H.; Hagenow, J.; Chung, M.-Y.; Hellio, C.; Weber, H.; Proksch, P. SAR of Sponge-inspired hemibastadin congeners inhibiting blue mussel phenoloxidase. Mar. Drugs 2015, 13, 3061–3071. [Google Scholar] [CrossRef]
- Bayer, M.; Hellio, C.; Marechal, J.P.; Frank, W.; Lin, W.; Weber, H.; Proksch, P. Antifouling bastadin congeners target mussel phenoloxidase and complex copper(II) Ions. Mar. Biotechnol. 2011, 13, 1148–1158. [Google Scholar] [CrossRef]
- Calcul, L.; Inman, W.D.; Morris, A.A.; Tenney, K.; Ratnam, J.; McKerrow, J.H.; Valeriote, F.A.; Crews, P. Additional insights on the bastadins: Isolation of analogues from the sponge Ianthella cf. reticulata and exploration of the oxime configurations. J. Nat. Prod. 2010, 73, 365–372. [Google Scholar] [CrossRef] [PubMed]
- Franklin, M.A.; Penn, S.G.; Lebrilla, C.B.; Lam, T.H.; Pessah, I.N.; Molinski, T.F. Bastadin 20 and bastadin O-sulfate esters from Ianthella basta: Novel modulators of the Ry1R FKBP12 receptor complex. J. Nat. Prod. 1996, 59, 1121–1127. [Google Scholar] [CrossRef] [PubMed]
- Greve, H.; Kehraus, S.; Krick, A.; Kelter, G.; Maier, A.; Fiebig, H.H.; Wright, A.D.; König, G.M. Cytotoxic bastadin 24 from the Australian sponge Ianthella quadrangulata. J. Nat. Prod. 2008, 71, 309–312. [Google Scholar] [CrossRef] [PubMed]
- Mathieu, V.; Wauthoz, N.; Lefranc, F.; Niemann, H.; Amighi, K.; Kiss, R.; Proksch, P. Cyclic versus hemi-bastadins. Pleiotropic anti-cancer effects: From apoptosis to anti-angiogenic and anti-migratory effects. Molecules 2013, 18, 3543–3561. [Google Scholar] [CrossRef] [PubMed]
- Le Norcy, T.; Niemann, H.; Proksch, P.; Tait, K.; Linossier, I.; Réhel, K.; Hellio, C.; Faÿ, F. Sponge-inspired dibromohemibastadin prevents and disrupts bacterial biofilms without toxicity. Mar. Drugs 2017, 15, 222. [Google Scholar] [CrossRef]
- Gartshore, C.J.; Salib, M.N.; Renshaw, A.A.; Molinski, T.F. Isolation of Bastadin-6-O-Sulfate and expedient purifications of Bastadins-4, −5 and −6 from extracts of Ianthella basta. Fitoterapia 2018, 126, 16–21. [Google Scholar] [CrossRef] [PubMed]
- Van Soest, R.W.M.; Boury-Esnault, N.; Hooper, J.N.A.; Rützler, K.; de Voogd, N.J.; Alvarez, B.; Hajdu, E.; Pisera, A.B.; Manconi, R.; Schönberg, C.; et al. World Porifera Database. Ianthella Flabelliformis (Linnaeus, 1759). Available online: http://www.marinespecies.org/aphia.php?p=taxdetails&id=169690 (accessed on 8 October 2019).
- Linnaeus, C. Systema Naturæ per Regna Tria Naturæ, Secundum Classes, Ordines, Genera, Species, Cum Characteribus, Differentiis, Synonymis, Locis; Vindobonae: Vienna, Austria, 1759. [Google Scholar] [CrossRef]
- Weuffen, W.; Berencsi, G.; Groschel, D.; Kemter, B.; Kramer, A.K.A.P. Handbuch der Antiseptik; Band 2: Antiseptika; Teil 3: Antibakterielle, Antifungielle und antivirale Antiseptik-Ausgewählte Wirkstoffe; VEB Verlag Volk und Gesundheit.: Berlin, Germany, 1987. [Google Scholar]
- Paliy, G.K.; Nazarchuk, O.A.; Kulakov, O.I.; Paliy, V.G.; Nazarchuk, S.A.; Paliy, D.V.; Kordon, Y.V.; Gonchar, O.O. Substaniation of antimicrobial dressings use in surgery. Med. Perspekt. 2014, 19, 152–158. [Google Scholar] [CrossRef]
- Klinger, C.; Żółtowska-Aksamitowska, S.; Wysokowski, M.; Tsurkan, M.V.; Galli, R.; Petrenko, I.; Machałowski, T.; Ereskovsky, A.; Martinović, R.; Muzychka, L.; et al. Express method for isolation of ready-to-use 3D chitin scaffolds from Aplysina archeri (Aplysineidae: Verongiida) demosponge. Mar. Drugs 2019, 17, 131. [Google Scholar] [CrossRef]
- Lendenfeld, R.L.R. Das hornfaserwachstum der aplysinidae. Zool. Anz. 1882, 5, 636. [Google Scholar]
- Carter, H.J. Contributions to our knowledge of the Spongida. Ann. Mag. Nat. Hist. 1881, 8, 241–259. [Google Scholar] [CrossRef][Green Version]
- Lendenfeld, R.L.R. A Monograph of the Horny Sponges; Triibner and Co.: London, UK, 1889. [Google Scholar]
- Polejaeff, N.N. Report on the Keratosa collected by H.M.S. Challenger during the years 1873–1876. In Report on the Scientific Results of the Voyage of H.M.S. Challenger during the Years 1873–1876; for Her Majesty’s Stationary Office, Zoology: London, UK; Edinburgh, Dublin, Ireland, 1884; pp. 1–88. [Google Scholar]
- De Laubenfels, M.W. The order of Keratosa of the phylum Porifera. A monographic study. Occ. Pap. Allan Hancock Found. 1948, 3, 1–217. [Google Scholar]
- Vacelet, J. Les cellules a inclusions de l’e ́ponge cornée Verongia cavernicola. J. Microsc. 1967, 6, 237–240. [Google Scholar]
- Turon, X.; Becerro, M.A.; Uriz, M.J. Distribution of brominated compounds within the sponge Aplysina aerophoba: Coupling of X-ray microanalysis with cryofixation techniques. Cell Tissue Res. 2000, 301, 311–322. [Google Scholar] [CrossRef] [PubMed]
- Bergquist, P.R.; de Cook, S.C. Order Verongida Bergquist, 1978. In Systema Porifera; Hooper, J.N.A., Van Soest, R.W.M., Willenz, P., Eds.; Springer: Boston, MA, USA, 2002; p. 1081. [Google Scholar]
- Carroll, A.R.; Kaiser, S.M.; Davis, R.A.; Moni, R.W.; Hooper, J.N.A.; Quinn, R.J. A bastadin with potent and selective δ-opioid receptor binding affinity from the Australian sponge Ianthella flabelliformis. J. Nat. Prod. 2010, 73, 1173–1176. [Google Scholar] [CrossRef] [PubMed]
- Motti, C.A.; Freckelton, M.L.; Tapiolas, D.M.; Willis, R.H. FTICR-MS and LC-UV/MS-SPE-NMR applications for the rapid dereplication of a crude extract from the sponge Ianthella flabelliformis. J. Nat. Prod. 2009, 72, 290–294. [Google Scholar] [CrossRef] [PubMed]
- Rogers, E.W.; Molinski, T.F. Highly polar spiroisoxazolines from the sponge Aplysina fulva. J. Nat. Prod. 2007, 70, 1191–1194. [Google Scholar] [CrossRef]
- Höfer, D. Antimicrobial Textiles – Evaluation of their effectiveness and safety. In Biofunctional Textiles and the Skin; Hipler, U.-C., Elsner, P., Eds.; Karger: Basel, Switzerland, 2006; pp. 42–50. [Google Scholar]
- Kramer, A.; Guggenbichler, P.; Heldt, P.; Jünger, M.; Ladwig, A.; Thierbach, H.; Weber, U.; Daeschlein, G. Hygienic relevance and risk assessment of antimicrobial-impregnated textiles. Curr. Probl. Dermatol. 2006, 33, 78–109. [Google Scholar] [PubMed]
- Elsner, P. Antimicrobials and the skin: Physiological and pathological flora. Curr. Probl. Dermatol. 2006, 33, 35–41. [Google Scholar]
- Gokarneshan, N.; Nagarajan, V.B.; Viswanath, S.R. Developments in antimicrobial textiles—Some insights on current research trends. Biomed. J. Sci Tech. Res. 2017, 1, 230–233. [Google Scholar]
- Freckelton, M.L.; Luter, H.M.; Andreakis, N.; Webster, N.S.; Motti, C.A. Qualitative variation in colour morphotypes of Ianthella basta (Porifera: Verongida). In Ancient Animals, New Challenges. Developments in Hydrobiology; Springer: Dordrecht, The Netherlands, 2011. [Google Scholar]
- Tabudravu, J.N.; Eijsink, V.G.H.; Gooday, G.W.; Jaspars, M.; Komander, D.; Legg, M.; Synstad, B.; Van Aalten, D.M.F. Psammaplin A, a chitinase inhibitor isolated from the Fijian marine sponge Aplysinella rhax. Bioorganic Med. Chem. 2002, 10, 1123–1128. [Google Scholar] [CrossRef]
- Ehrlich, H.; Bazhenov, V.V.; Debitus, C.; de Voogd, N.; Galli, R.; Tsurkan, M.V.; Wysokowski, M.; Meissner, H.; Bulut, E.; Kaya, M.; et al. Isolation and identification of chitin from heavy mineralized skeleton of Suberea clavata (Verongida: Demospongiae: Porifera) marine demosponge. Int. J. Biol. Macromol. 2017, 104, 1706–1712. [Google Scholar] [CrossRef] [PubMed]
- Shaala, L.A.; Asfour, H.Z.; Youssef, D.T.A.; ółtowska-Aksamitowska, S.Z.; Wysokowski, M.; Tsurkan, M.; Galli, R.; Meissner, H.; Petrenko, I.; Tabachnick, K.; et al. New source of 3D chitin scaffolds: The red sea demosponge Pseudoceratina arabica (pseudoceratinidae, verongiida). Mar. Drugs 2019, 17, 92. [Google Scholar] [CrossRef] [PubMed]
- Shang, Y.; Ding, F.; Xiao, L.; Deng, H.; Du, Y.; Shi, X. Chitin-based fast responsive pH sensitive microspheres for controlled drug release. Carbohydr. Polym. 2014, 102, 413–418. [Google Scholar] [CrossRef]
- Zhou, D.; Yang, R.; Yang, T.; Xing, M.; Gaoxing, L.G. Preparation of chitin-amphipathic anion/quaternary ammonium salt ecofriendly dressing and its effect on wound healing in mice. Int. J. Nanomed. 2018, 13, 4157–4169. [Google Scholar] [CrossRef] [PubMed]
- Dement’eva, O.V.; Naumova, K.A.; Senchikhin, I.N.; Roumyantseva, T.B.; Rudoy, V.M. Sol--gel synthesis of mesostructured SiO2 containers using vesicles of hydrolyzable bioactive gemini surfactant as a template. Colloid J. 2017, 79, 451–458. [Google Scholar] [CrossRef]
- Shchetina, V.N.; Belanov, E.F.; Starobinets, Z.G.; Volianskiĭ, I. The effect of dexamethoxin on the integrity of cytoplasmic membrane in gram-positive and gram-negative microorganisms. Mikrobiol. Zh 1990, 52, 24–28. [Google Scholar] [PubMed]
- Nazarchuk, O.A.; Chereshniuk, I.L.; Nazarchuk, H.H. The research of antimicrobial efficacy of antiseptics decamethoxin, miramistin and their effect on nuclear DNA fragmentation and epithelial cell cycle. Wiad. Lek. 2019, 72, 374–380. [Google Scholar]
- Fuss, J.; Palii, V.; Voloboyeva, A. evaluating the effectivenes of antiseptic solution decasan in treatment of necrotic soft tisue diseases. Pol. Przegl. Chir. 2016, 88, 233–237. [Google Scholar] [CrossRef]
- Paliy, G.K.; Lukhimel, A.D.; Onofreĭchuk, I.F. Disinfection of surgical silk with decamethoxin, antibiotics and their combinations. Antibiotiki 1978, 88, 629–633. [Google Scholar]
- Galatenko, N.A.; Nechaeva, L.; Bufius, N.N. Possibilities of the chemical sterilization of soft contact lenses made of polyacrylamide. Gig. Sanit. 1991, 7, 67–68. [Google Scholar]
- Ritger, P.L.; Peppas, N.A.A. Fickian and non-Fickian release from non-swellable devices in the form of slabs, spheres, cylinders or discs. J. Control. Release 1987, 5, 23–36. [Google Scholar] [CrossRef]
- Peppas, A.N. Analysis of Fickian and non-Fickian drug release from polymers. Pharm. Acta Helv. 1985, 60, 110–111. [Google Scholar]
- He, C.; Nie, W.; Feng, W. Engineering of biomimetic nanofibrous matrices for drug delivery and tissue engineering. J. Mater. Chem. B 2014, 2, 7828–7848. [Google Scholar] [CrossRef]
- Prabu, P.; Kim, K.W.; Dharmaraj, N.; Park, J.H.; Khil, M.S.; Kim, H.Y. Antimicrobial drug release scaffolds of natural and synthetic biodegradable polymers. Macromol. Res. 2008, 16, 303–307. [Google Scholar] [CrossRef]
- Kamaly, N.; Yameen, B.; Wu, J.; Omid, C.; Farokhzad, O.C. Degradable controlled-release polymers and polymeric nanoparticles: Mechanisms of controlling drug release. Chem. Rev. 2016, 116, 2602–2663. [Google Scholar] [CrossRef]
- Erpenbeck, D.; Voigt, O.; Al-Aidaroos, A.M.; Berumen, M.L.; Büttner, G.; Catania, D.; Guirguis, A.N.; Paulay, G.; Schätzle, S.; Wörheide, G. Molecular biodiversity of Red Sea demosponges. Mar. Pollut. Bull. 2016, 105, 507–514. [Google Scholar] [CrossRef]
- Spurr, A.R. A low-viscosity epoxy resin embedding medium for electron microscopy. J. Ultrastruct. Res. 1969, 26, 31–43. [Google Scholar] [CrossRef]
- Reynolds, E.S. The use of lead citrate at high pH as an electron-opaque stain in electron microscopy. J. Cell Biol. 1963, 208–212. [Google Scholar] [CrossRef]

© 2019 by the authors. Licensee MDPI, Basel, Switzerland. This article is an open access article distributed under the terms and conditions of the Creative Commons Attribution (CC BY) license (http://creativecommons.org/licenses/by/4.0/).
Share and Cite
Kovalchuk, V.; Voronkina, A.; Binnewerg, B.; Schubert, M.; Muzychka, L.; Wysokowski, M.; Tsurkan, M.V.; Bechmann, N.; Petrenko, I.; Fursov, A.; et al. Naturally Drug-Loaded Chitin: Isolation and Applications. Mar. Drugs 2019, 17, 574. https://doi.org/10.3390/md17100574
Kovalchuk V, Voronkina A, Binnewerg B, Schubert M, Muzychka L, Wysokowski M, Tsurkan MV, Bechmann N, Petrenko I, Fursov A, et al. Naturally Drug-Loaded Chitin: Isolation and Applications. Marine Drugs. 2019; 17(10):574. https://doi.org/10.3390/md17100574
Chicago/Turabian StyleKovalchuk, Valentine, Alona Voronkina, Björn Binnewerg, Mario Schubert, Liubov Muzychka, Marcin Wysokowski, Mikhail V. Tsurkan, Nicole Bechmann, Iaroslav Petrenko, Andriy Fursov, and et al. 2019. "Naturally Drug-Loaded Chitin: Isolation and Applications" Marine Drugs 17, no. 10: 574. https://doi.org/10.3390/md17100574
APA StyleKovalchuk, V., Voronkina, A., Binnewerg, B., Schubert, M., Muzychka, L., Wysokowski, M., Tsurkan, M. V., Bechmann, N., Petrenko, I., Fursov, A., Martinovic, R., Ivanenko, V. N., Fromont, J., Smolii, O. B., Joseph, Y., Giovine, M., Erpenbeck, D., Gelinsky, M., Springer, A., ... Ehrlich, H. (2019). Naturally Drug-Loaded Chitin: Isolation and Applications. Marine Drugs, 17(10), 574. https://doi.org/10.3390/md17100574










